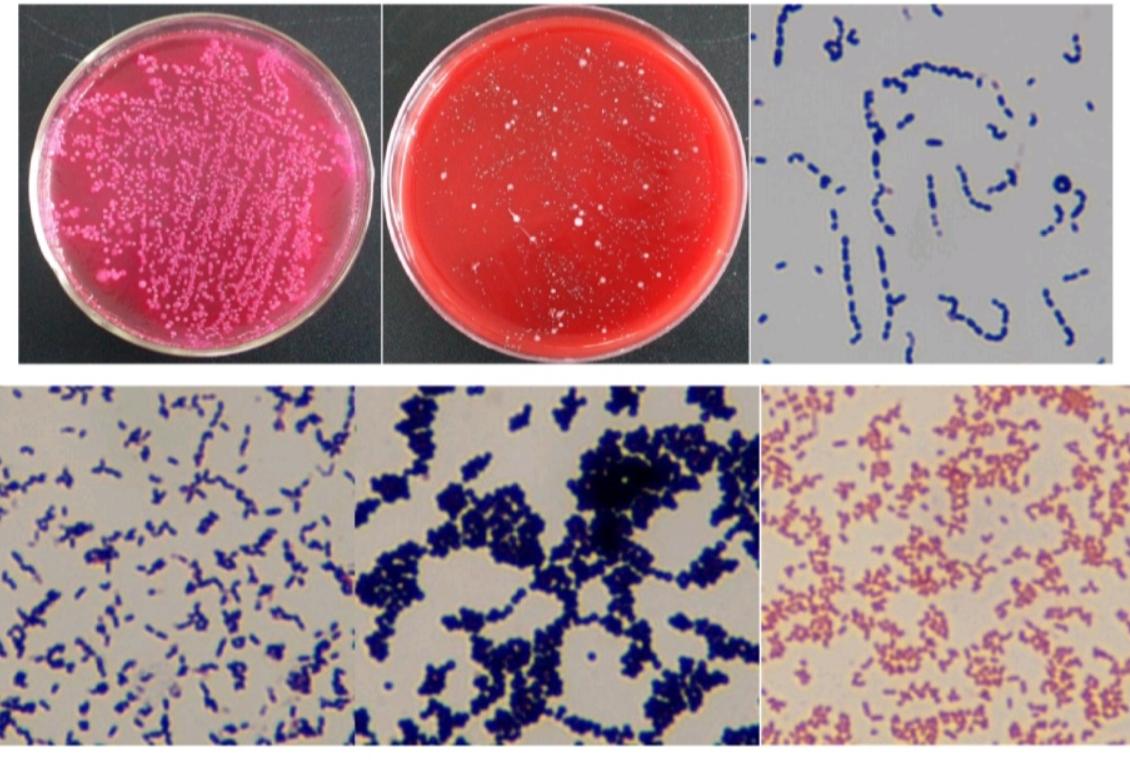
20斤左右的小猪拉稀是什么病,小猪出生几天拉稀死亡是什么原因
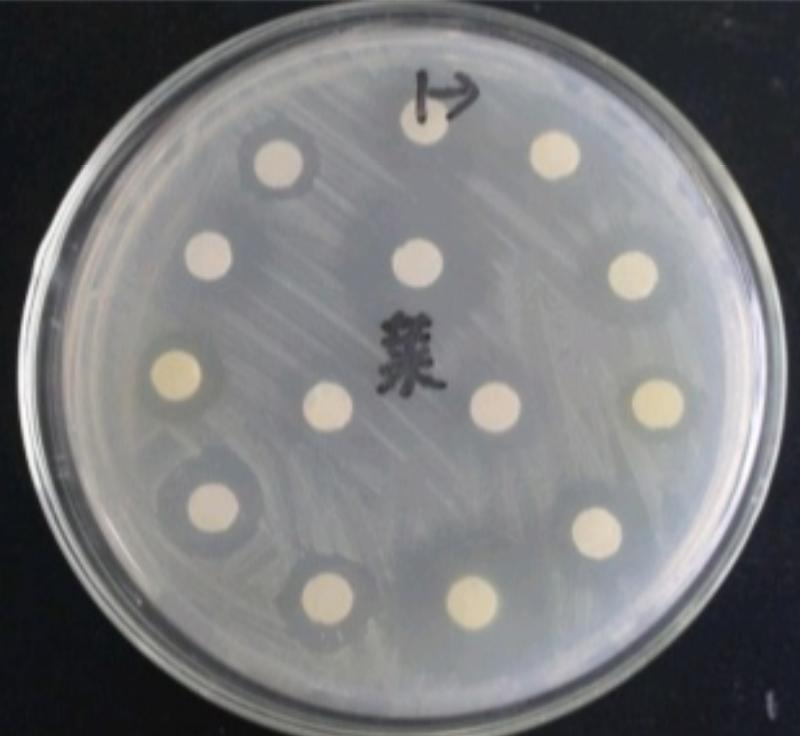
20斤左右的小猪拉稀是什么病,小猪出生几天拉稀死亡是什么原因

今天接到一个朋友(头条号--乡村猪事录)的电话,他们实验室在前几天接触到一个案例,本身非常少见但是最近几天在烟台当地已经发生了三起了,希望我发布出来提醒广大农民养殖户朋友。
这家发病猪场,起始是20斤左右小猪有腹泻,请了当地的几位兽医也都给出了不同的答案,有人说是猪瘟、有人说是沙门氏菌、有人说是大肠杆菌。猪场老板听取意见,在饲料中加过阿莫西林、氟苯尼考和板青颗粒等药物,加药2天后小猪开始出现死亡,前后3天内共死亡20多头,农民养殖户就带了两头死亡小猪到朋友的检测中心希望借助实验室的检测手段帮忙确诊。

左图为稍小猪,右图为稍大猪
一、病理剖检
其中一头稍大死亡小猪:背部和耳根呈现紫红色,体表其它部位未见明显眼观变化,对死亡小猪进行病理解剖发现,小猪的腹股沟淋巴结肿大,呈水肿状态;扁桃体潮红,但未见出血点和坏死灶;肺脏有气肿和出血,颜色明显深于正常肺脏颜色;脾脏表面有出血泡,边缘有少量梗死灶;肾脏肿大水肿,左右肾大小相差较大,肾乳头出血;心肌出血;结肠浆膜出血,有白色结节;肠系膜淋巴结肿大充血。
另一头稍小死亡小猪:腹股沟淋巴结出血,肿大;肺脏病变不明显,但颜色深于正常肺脏颜色;脾脏边缘有出血泡;肾脏皮质表面有白斑,肾乳头出血;结肠浆膜有白色结节;肠粘膜出血,肠系膜淋巴结肿大出血。
根据病理解剖症状,初步诊断可能有小袋纤毛虫、沙门氏菌、猪瘟、蓝耳、圆环病毒Ⅱ型和伪狂犬野毒感染,安排显微镜检小袋纤毛虫,细菌分离检测沙门氏菌,PCR检测猪瘟、蓝耳、圆环病毒Ⅱ型和伪狂犬感染。
二、检测结果
1、显微镜检测结果
使用送检小猪的结肠内容物制作触片,在显微镜下镜检,可发现明显的小袋纤毛虫,如下图所示:

显微镜下的小袋纤毛虫,可作为诊断依据
2、细菌分离检测结果和药敏试验结果
采用无菌操作取送检稍小猪结肠内容物涂布DHL(胆硫乳)平板,取送检稍大猪肺脏涂布血平板,将两个平板分别置于37℃温箱中过夜,在DHL平板上未见黑色的沙门氏菌典型菌落,而在血平板上长出大量菌落,跳去单个菌落进行革兰氏染色镜检,结果分别为葡萄球菌、链球菌和绿脓杆菌(结果如下图所示)。
上左一为DHL平板,上左二为血平板,上右一和下左一为链球菌,下左二为葡萄球菌,下右一为绿脓杆菌
无菌操作取送检病死猪的肠内容物涂布MHA平板,按照图中箭头方向贴药敏纸片,分别为:庆大霉素、头孢喹肟、恩诺沙星、强力霉素、氟苯尼考、恩诺沙星、硫酸粘杆菌素、新霉素、强力霉素、泰妙菌素、阿莫西林、丁胺卡那霉素、林可大观霉素、头孢噻呋,结果如下图所示:
药敏试验结果:分离的细菌对恩诺沙星和丁胺卡那霉素高度敏感;对庆大霉素、头孢喹肟、恩诺沙星、氟苯尼考、硫酸粘杆菌素、新霉素、强力霉素、泰妙菌素和阿莫西林中度敏感;对林可大观霉素、头孢噻呋低度敏感。
药敏试验结果
3、PCR检测结果
取送检猪的脾脏、肺脏、扁桃体、淋巴结组织匀浆后进行病毒PCR检测,下图中1-3泳道为送检猪组织样品猪瘟病毒检测泳道,4-6泳道为送检猪组织样品蓝耳病毒检测泳道,7泳道为送检猪组织样品圆环病毒Ⅱ型检测泳道,8泳道为送检猪组织样品伪狂犬野毒检测泳道,M为DNA Marker泳道。
结果显示:送检猪组织样品中检测有圆环病毒Ⅱ型和猪瘟病毒弱阳性,而蓝耳病毒和伪狂犬野毒为阴性。

PCR检测结果
三、结果与分析
通过上述显微镜检、细菌分离检测和PCR检测可以得出 结论,送检小猪肠道中检测有小袋纤毛虫,而未检测到沙门氏菌,在稍大猪的肺脏中检测到有链球菌、葡萄球菌和绿脓杆菌。对肠道分离细菌进行药敏试验发现,高敏药物只有恩诺沙星和丁胺卡那霉素。PCR检测结果显示,送检病死猪检测到有圆环病毒Ⅱ型和猪瘟弱阳性。
根据结果分析突然死亡小猪是在之前已经感染了慢性猪瘟和圆环病毒Ⅱ型,猪群抵抗力下降后肺脏感染了链球菌、葡萄球菌等细菌性疾病,而肠道感染了小袋纤毛虫导致小猪腹泻,并最终急性死亡。
四、解决方案
根据检测结果,提供给这位养殖户朋友的解决方案如下:
- 1、腹泻病猪肌注甲硝唑注射液或者地美硝唑注射液,连用3天;
- 2、病猪的饲料中加入恩诺沙星+黄芪多糖粉+板蓝根颗粒,连用7天后去掉恩诺沙星再用7天。
- 3、饮水中添加氨基多维,连用7天;
- 4、全场母猪紧急免疫猪瘟疫苗2头份/头,间隔4周后再补免一次。而圆环在猪瘟疫苗免疫后一个星期免疫2mL,间隔4周后加强免疫一次。仔猪在出生后14日龄免疫圆环疫苗1mL。

小袋纤毛虫病科普
小袋纤毛虫是一种寄生于猪结肠上皮细胞内的原虫,属于人兽共患病,猪场多见于刚断奶仔猪。仔猪发病后的主要症状为腹泻,粪便起始呈粥状,后转为水样腹泻,严重时排泄物中夹杂有粘膜碎片和血液。发病仔猪多呈急性发病,发病后2-3天内即出现死亡。
治疗措施:猪场发病后要加*卫强**生清理和消毒工作,及时清除病猪粪便并做好堆积发酵。对于病猪最好隔离饲养,同时可在饲料中加入黄连素+甲硝唑或地美硝唑,连用7天。严重时可肌注甲硝唑注射液。